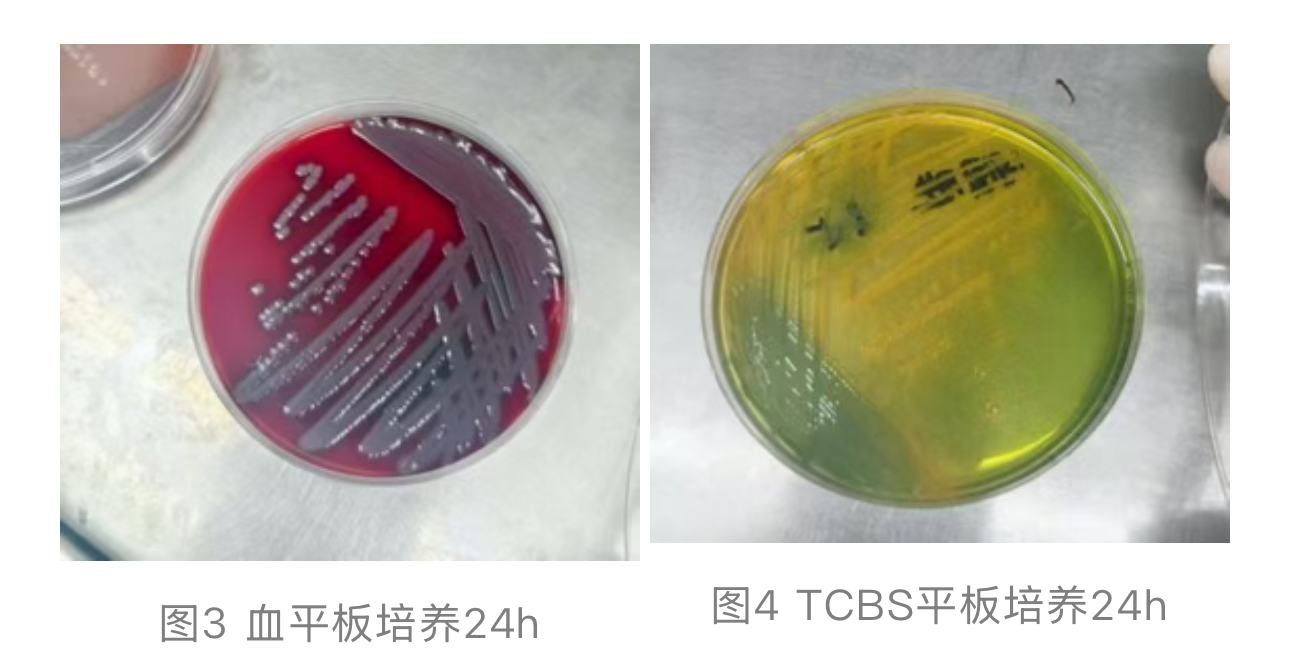
1762992680539165.jpg 1762992680539165.jpg

胆管癌术后突发高烧寒战,血培养揭穿非霍乱弧菌在“作祟”
作者:谢婷婷 刘红军 靳力敬等,濮阳市中医医院检验科
前言
霍乱弧菌 (Vibrio cholerae)是一种菌体呈直、微弯或逗点状,嗜盐,兼性厌氧,具有单鞭毛或多个鞭毛、无芽孢和荚膜,运动活泼的革兰阴性小杆菌,广泛分布于海洋和河口环境,通常通过粪 - 口途径传播,根据血清型差异,可将其分为 O1 群、O139 群以及非 O1/O139 群霍乱弧菌(non-O1/O139 Vibrio cholerae, NOVC)。
(Vibrio cholerae)是一种菌体呈直、微弯或逗点状,嗜盐,兼性厌氧,具有单鞭毛或多个鞭毛、无芽孢和荚膜,运动活泼的革兰阴性小杆菌,广泛分布于海洋和河口环境,通常通过粪 - 口途径传播,根据血清型差异,可将其分为 O1 群、O139 群以及非 O1/O139 群霍乱弧菌(non-O1/O139 Vibrio cholerae, NOVC)。
O1、O139 群可产生霍乱毒素(CT,由 ctxAB 编码)和毒素共调菌毛(TCP,由 tcpA 编码),引起典型的霍乱样腹泻 。相比之下,NOVC 菌株通常不携带 ctxAB 和 tcpA 基因,不引起大规模流行性霍乱,其致病机制复杂,涉及多种毒力因子,如外膜蛋白(ompW)、脂多糖(LPS)、肠毒素(ST)、蛋白酶、溶血素(HlyA)、磷脂酶(PL)、转录调节因子(ToxR)、重复毒素(RTX)、粘附素蛋白酶(Hap)以及三型分泌系统(TTSS)[7,8] 等。由于 NOVC 菌株间遗传背景差异显著,其临床表现具有高度异质性 [3],既可导致非流行性腹泻,也可引起肠道外感染,如菌血症,后者在临床上较为罕见 [1,2,9]。本文通过一例胆管恶性肿瘤术后感染 NOVC 的案例,探讨其临床特点、诊断与治疗策略。
。相比之下,NOVC 菌株通常不携带 ctxAB 和 tcpA 基因,不引起大规模流行性霍乱,其致病机制复杂,涉及多种毒力因子,如外膜蛋白(ompW)、脂多糖(LPS)、肠毒素(ST)、蛋白酶、溶血素(HlyA)、磷脂酶(PL)、转录调节因子(ToxR)、重复毒素(RTX)、粘附素蛋白酶(Hap)以及三型分泌系统(TTSS)[7,8] 等。由于 NOVC 菌株间遗传背景差异显著,其临床表现具有高度异质性 [3],既可导致非流行性腹泻,也可引起肠道外感染,如菌血症,后者在临床上较为罕见 [1,2,9]。本文通过一例胆管恶性肿瘤术后感染 NOVC 的案例,探讨其临床特点、诊断与治疗策略。
病例摘要
患者,闫先生,65 岁,行胆管恶性肿瘤胰十二指肠切除术,术后恢复尚可,2025 年 5 月因腹痛加剧就诊,MRI 显示肿瘤进展,化疗后出现消化道反应,1 天前患者发热 寒战、乏力,右上腹疼痛,无呕吐
寒战、乏力,右上腹疼痛,无呕吐 腹泻,二便正常,以 “胆管恶性肿瘤术后发热待查:胆管炎
腹泻,二便正常,以 “胆管恶性肿瘤术后发热待查:胆管炎 ” 收入我院,既往无慢性病或传染病史。
” 收入我院,既往无慢性病或传染病史。
初步判断:中医:胆癌(痰瘀互结、寒热错杂证);西医:胆管恶性肿瘤;发热待查:胆管炎?
【辅助检查】
1.实验室检查显示感染指标升高:WBC:7.57×10⁹/L、中性粒细胞百分比 80.1%↑、IL-6:212.1pg/ml↑、PCT:0.10ng/ml↑、超敏 CRP:67.37mg/L↑、CA19-9:183.52U/mL↑、SAA143.24μg/mL↑等。血培养 瓶报阳(约2小时),提示细菌负荷量高、生长迅速,革兰染色涂片
瓶报阳(约2小时),提示细菌负荷量高、生长迅速,革兰染色涂片 见革兰阴性杆菌(见图 1),瑞氏染色更清晰,可见弯曲的杆菌(见图 2)。
见革兰阴性杆菌(见图 1),瑞氏染色更清晰,可见弯曲的杆菌(见图 2)。

培养 24 小时后,血平板上可见 β 溶血、湿润、绿色金属样光泽的菌落(见图 3),TCBS 平板上为黄色隆起菌落(见图 4)。
挑取纯培养菌落进行革兰染色,镜下可见弧状、逗点状、鱼群样排列,菌体短小的革兰阴性杆菌(见图 5),悬滴镜检显示运动活泼、呈穿梭样运动的弧菌,经中元质谱仪鉴定为霍乱弧菌(见图 6)。
立即前往当地疾控中心做血清凝集试验,显示 O1 及 O139 抗血清均为阴性,生理盐水对照无凝集,确认为 NOVC。实验室及时向临床科室报告,并说明 NOVC 不属于法定甲类传染病病原体,无需进行疫情上报,同时通知医院感染控制科备案。药敏试验 依据 CLSI M45 弧菌属折点采用 K-B 法进行(见图 7),结果显示对常用抗生素敏感;及时跟临床沟通,提示临床采集肛周拭子和粪便送检,培养 2 天后,未检出霍乱弧菌。
依据 CLSI M45 弧菌属折点采用 K-B 法进行(见图 7),结果显示对常用抗生素敏感;及时跟临床沟通,提示临床采集肛周拭子和粪便送检,培养 2 天后,未检出霍乱弧菌。
2.影像学提示肝内异常回声/低密度灶,不排除肝脓肿或胆管积气
【最终诊断】中医:胆癌(痰瘀互结证,寒热错杂);西医诊断:胆管恶性肿瘤;胆管炎;感染性发热。
【诊疗经过】入院后西医治疗予以磷霉素 注射液、莫西沙星
注射液、莫西沙星 注射液、地塞米松磷酸钠注射液
注射液、地塞米松磷酸钠注射液 及0.9%氯化钠注射液
及0.9%氯化钠注射液 进行抗感染及营养支持治疗,后根据NOVC药敏结果,将磷霉素调整为头孢哌酮
进行抗感染及营养支持治疗,后根据NOVC药敏结果,将磷霉素调整为头孢哌酮 钠舒巴坦
钠舒巴坦 钠,中医方面予复方苦参注射液
钠,中医方面予复方苦参注射液 、热毒宁注射液
、热毒宁注射液 清热解毒止痛,复方斑蝥胶囊
清热解毒止痛,复方斑蝥胶囊 口服以解毒散结,黄芪注射液
口服以解毒散结,黄芪注射液 足三里穴位注射以健脾扶正,中药贴敷神阙穴以健脾益胃,中药汤剂辨证予养阴疏肝、解毒散结之剂。治疗23天后,患者腹痛明显缓解,感染指标下降,经评估后准予出院。出院带抗肿瘤药物替卡奥胶囊,卡培他滨片
足三里穴位注射以健脾扶正,中药贴敷神阙穴以健脾益胃,中药汤剂辨证予养阴疏肝、解毒散结之剂。治疗23天后,患者腹痛明显缓解,感染指标下降,经评估后准予出院。出院带抗肿瘤药物替卡奥胶囊,卡培他滨片 。
。
案例分析与探讨
1.实验室检查与处理:根据我国《人间传染的病原微生物目录》,霍乱弧菌的检测及活菌操作可在生物安全二级实验室内进行。自临床样本中分离出疑似霍乱弧菌时,应使用商品化细菌生化反应鉴定卡(如 API 卡,需注意调整 NaCl 浓度以促进弧菌生长)、MALDI-TOF MS、自动化微生物鉴定系统及 16S rRNA 测序等多种方法确保准确鉴定,同时应具备快速血清凝集试验分型或 ctxAB PCR 检测能力。鉴于 O1 群、O139 群菌株具有强烈致病性和传染性,一旦确认须立即上报并启动霍乱防控流程;而对 NOVC 感染,应根据患者实际情况采取适度感染控制措施,避免疫情误报,造成过度处置和医疗资源浪费 [8]。
2.感染途径推测:NOVC 导致血流感染的具体机制尚不明确。本例患者因胆肠吻合术后解剖结构改变,推测病原体可能经由未煮熟海鲜等食物进入肠道,反流至胆道,进而形成肝脓肿并入血引发菌血症。NOVC 菌血症病例在 6-8 月较为常见,主要分布在沿海省份和长江流域 [8]。
该菌属机会性病原体,多见于伴有基础疾病或免疫低下人群,如慢性肝脏疾病 [5,6]、血液病 [4]、肿瘤患者 [2],偶见于免疫功能正常的健康人群 [9]。NOVC 约 10% 的分离株来自伤口感染,10% 来自中耳炎
[4]、肿瘤患者 [2],偶见于免疫功能正常的健康人群 [9]。NOVC 约 10% 的分离株来自伤口感染,10% 来自中耳炎 ,20% 来自菌血症(肝病患者易发)[10];我国肝病患病率很高,临床医生与公共卫生人员应警惕此类感染 [8],本例亦属于此。
,20% 来自菌血症(肝病患者易发)[10];我国肝病患病率很高,临床医生与公共卫生人员应警惕此类感染 [8],本例亦属于此。
患者为肠外感染所致菌血症,症状以发热、寒战为主,无典型霍乱腹泻(米泔水样便)表现,且细菌检出于血培养,肛周拭子和粪便未培养出霍乱弧菌,极有可能为 NOVC,可按一般细菌感染处理;对于免疫功能低下或存在潜在肝病的患者,建议进行抗菌治疗。
3.药敏指南:NOVC 分离株通常对 β 内酰胺类、氟喹诺酮类、复方磺胺甲噁唑 、四环素
、四环素 和氯霉素
和氯霉素 等抗菌药物敏感 [2]。治疗首选阿奇霉素
等抗菌药物敏感 [2]。治疗首选阿奇霉素 、红霉素
、红霉素 、多西环素
、多西环素 / 四环素或环丙沙星
/ 四环素或环丙沙星 ,疗程均为 3 天 [11]。耐药率较高的抗菌药物包括氨苄西林
,疗程均为 3 天 [11]。耐药率较高的抗菌药物包括氨苄西林 / 舒巴坦(37.5%)、阿莫西林
/ 舒巴坦(37.5%)、阿莫西林 / 克拉维酸(33.3%)、氨苄西林(29.2%)和磺胺甲噁唑(20%),目前未见广泛多重耐药报道 [3]。
/ 克拉维酸(33.3%)、氨苄西林(29.2%)和磺胺甲噁唑(20%),目前未见广泛多重耐药报道 [3]。
4.思考:为何霍乱弧菌多见于免疫力低下人群?Knut Drescher 团队在《Cell》发表的研究指出,这可能与霍乱弧菌生物膜的形成及其对免疫细胞的杀伤作用有关。他们通过研究霍乱弧菌和免疫细胞的相互作用发现,霍乱弧菌生物膜的形成不仅是一种保护性状,更是一种攻击性状 —— 它们利用生物膜作为一种侵略性武器,借助血凝素菌毛、TCP 菌毛和定植因子 TcpF 等因子集体行动,包裹并加强对免疫细胞的杀伤,从而减少周围环境中的吞噬细胞数量,因此免疫力低下人群更易发生霍乱弧菌定植感染并引发症状。这一多细胞捕食策略颠覆了传统 “免疫细胞猎杀细菌” 的认知 [7],为理解其致病机制提供了新视角。
总结
1. 非 O1/O139 群≠霍乱,遇到时不必过于惊慌;2. 胆管术后因解剖结构改变易发生感染,需高度警惕;3. 感染多与食用海鲜或接触海水有关,术后患者应注重饮食安全;4. 多学科协作(临床、微生物、影像)对精准诊断与治疗至关重要。
参考文献略。
来源:检验医学网
